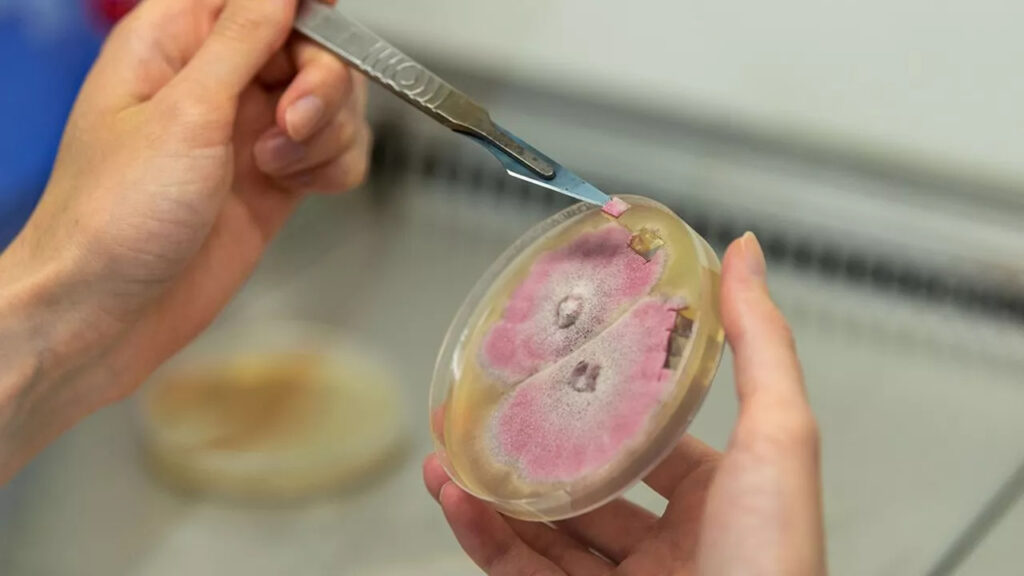

Mycea in Les Échos – a leading French national business newspaper
Mycea is gaining recognition in the Ag Biotech ecosystem for its innovative approach to crop protection using forest fungi extracts. Les Échos Coverage – December 1, 2025 “Mycea uses mushroom extracts to protect crops from diseases” Les Échos, France’s leading business newspaper, features Mycea’s mission to develop natural biocontrol solutions from forest fungi. The article […]
MYCEA in La Lettre M, a regional economic newsletter.

In its January 7th edition, the business monthly La Lettre M highlights our development strategy and the creation of a spin-off dedicated to commercializing soil biodiversity regeneration solutions. After 5 years of R&D within MYCEA, the soil biodiversity regeneration activity through amplification of native mycorrhizal fungi from each terroir is giving birth to Amoterra, a […]